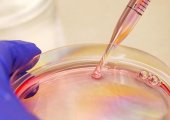

首页 > 楚天








这个黄金周,有两件事让人感到意外:第一是黄金大跌,美元继续疯狂;第二是恒大在宣布许家印出事后,复牌竟然不是暴跌,而是暴涨。


亚美尼亚的国会10月3日通过加入国际刑事法院(ICC),由于俄罗斯总统普京(Vladimir Putin)正被ICC通缉,这意味普京访问该国将可能被捕,同时显示普京正失去前苏联盟友的支持。

在包括印度在内的29个国家纷纷与美国签署《阿耳忒弥斯协议》重返月球计划之际,一心想与华盛顿竞争的北京邀请各国参与其月球任务“嫦娥8号”,但门庭冷落。




英国广播公司(BBC)报导,巴基斯坦警方逮捕了该国东北部一个器官贩运集团的8名成员。集团首脑穆赫塔(FawadMukhtar)被控从逾300人身上活摘肾脏,再将器官卖给富人客户。

都不持久,因此需要疫苗追加剂,而有些人会也会反复感疫。为何我们的免疫系统如此健忘?现在科学家终于找到原因,可能某个特定的分子通道无法长期保持,或许将来只要把这个通道持续开启,免疫效果也可以持久一些。






在华府抢案数量激增之际,德州民主党籍联邦众议员奎拉(Henry Cuellar)的幕僚表示,奎拉今天晚上在华府住家外遭遇劫车事件。





哥伦比亚一名女子自称,过去20年间,每晚都跟鬼“发生关系”,期间甚至爱上了鬼魂,不过,她后来见到鬼魂真面目后,才冷静下来结束此关系。









越南一名人妻2018年遭拐卖至中国当新娘,直到今年9月中旬才被救出。越南今年上半年共有88起人口贩运案、计224人受害,而中国性别严重失衡,对“越南新娘”的需求尤其旺盛。


美国F-35隐形战机专案问题层出不穷、检讨声不断,即将打破自创的世界最贵纪录,在开发和采购成本狂飙下,推升到4,380亿美元(约14.2兆台币)。


俄罗斯国家能源控股公司Inter RAO周一(10月2日)表示,已开始限制对中国的电力供应,同时有关涨价的谈判正在进行中。


英国外交大臣柯维立(James Cleverly)警告,北京当局若对台湾开战,中国经济将会崩溃。他坚称,英国对中国有影响力,因为中方担心与西方贸易减少。







中国开启中秋节加“十一”8天连假,当地出游民众大增,许多路段涌入大量车潮,挤得水泄不通,一名男子开夜车堵在广东佛山高架桥上,因着尿急竟将桥边围栏误认为绿化带分隔岛,当场一跃而下惨摔桥底。